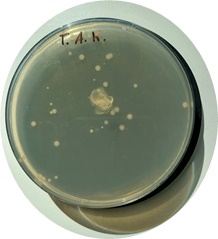

| |
|
|
|
|
|
|
|
|
|
|
|
|
|
|
|
|
|
|
|
|
|
|
|
|
|
|
|
|
|
|
| |
|
Am 15. 08. dieses
Jahres besuchten wir im Rahmen des naturwisssenschaftlichen
Praktikums des GSO-Leistungskurses das neue DLR_School_Lab der
Hochschule Zittau/Görlitz. |
|
| |
|
|
| |
|
|
|
|
|
|
|
|
|
|
|
|
|
|
|
|
|
|
|
|
|
|
|
|
|
|
|
|
|
|
| |
 |
 |
|
| |
|
| |
|
| |
|
| |
|
| |
|
| |
|
| |
|
| |
|
| |
|
| |
|
| |
 |
|
| |
|
| |
|
| |
|
| |
|
| |
|
| |
|
| |
|
| |
Ziel des
Besuchs war es, naturwissenschaftliche Untersuchungsmethoden und
labortechnisches Arbeiten der Schüler als Vorbereitung der
Projektarbeiten in Klasse 13 zu schulen. Dazu führten die
Schüler eine Reihe an Versuchen durch: |
|
|
|
|
|
|
|
|
|
|
|
|
| |
|
|
|
| |
● |
Anzucht
von Bakterienkulturen auf Nährmedien |
|
|
|
| |
● |
spektroskopische Untersuchung von Pflanzenextrakten |
|
|
|
| |
● |
dünnschichtchromatographische Untersuchung von Pflanzenextrakten |
|
|
|
| |
● |
Aufnahme
der Titrationskurve von ein- und mehrwertigen Protolyten |
|
|
|
| |
● |
lichtmikroskopische
und fluoreszenzmikroskopische Untersuchung von Pflanzengeweben |
|
|
|
| |
|
|
|
|
|
|
|
|
|
|
|
|
|
|
|
|
|
|
|
|
|
|
|
|
|
|
|
|
|
|
| |
 |
 |
 |
|
| |
|
| |
|
| |
|
| |
|
| |
|
| |
|
| |
|
| |
|
|
|
|
|
|
|
|
|
|
|
|
|
|
|
|
|
|
|
|
|
|
|
|
|
|
|
|
|
|
| |
 |
|
|
|
|
|
|
|
|
|
 |
|
| |
|
|
|
|
|
|
|
|
|
|
| |
Wir
danken allen Mitarbeitern und besonders Herrn Dr. Fester für die
Vorbereitung der Experimente und die kompetente Betreuung und
freuen uns auf weitere Besuche. |
|
| |
|
| |
|
| |
|
| |
|
|
|
|
|
|
|
|
|
|
| |
|
|
|
|
|
|
|
|
|
|
| |
|
|
|
|
|
|
|
|
|
|
|
|
|
|
|
|
|
|
|
|
| |
|
|
|
|
|
|
|
|
|
|
|
|
|
|
|
|
|
|
|
|
|
|
|
|
|
|
|
|
|
|
| |
|
|
|
|
|
|
|
|
|
|
|
|
|
|
|
|
|
|
|
Text+Bilder:
Herr Ch. Engemann |
|